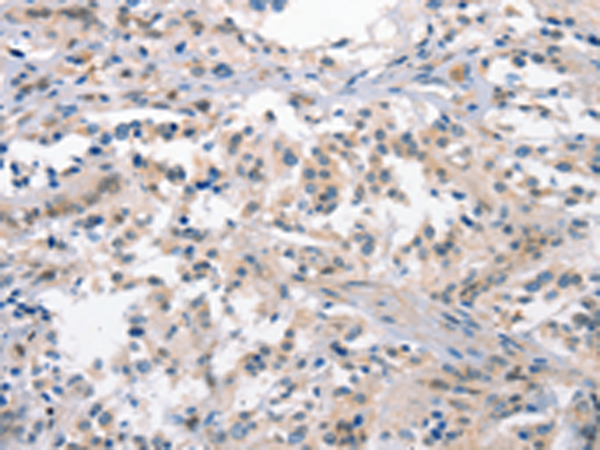

中文名稱(chēng):兔抗CRHR1多克隆抗體
|
Background: |
This gene encodes a G-protein coupled receptor that binds neuropeptides of the corticotropin releasing hormone family that are major regulators of the hypothalamic-pituitary-adrenal pathway. The encoded protein is essential for the activation of signal transduction pathways that regulate diverse physiological processes including stress, reproduction, immune response and obesity. Alternative splicing results in multiple transcript variants, one of which represents a read-through transcript with the neighboring gene MGC57346. |
|
Applications: |
ELISA, IHC |
|
Name of antibody: |
CRHR1 |
|
Immunogen: |
Synthetic peptide of human CRHR1 |
|
Full name: |
corticotropin releasing hormone receptor 1 |
|
Synonyms: |
CRF1; CRHR; CRF-R; CRFR1; CRF-R1; CRFR-1; CRH-R1; CRHR1L; CRHR1f; CRF-R-1; CRH-R-1; CRH-R1h |
|
SwissProt: |
P34998 |
|
ELISA Recommended dilution: |
1000-2000 |
|
IHC positive control: |
Human thyroid cancer |
|
IHC Recommend dilution: |
15-50 |
購(gòu)物車(chē)
購(gòu)物車(chē) 幫助
幫助
 021-54845833/15800441009
021-54845833/15800441009
